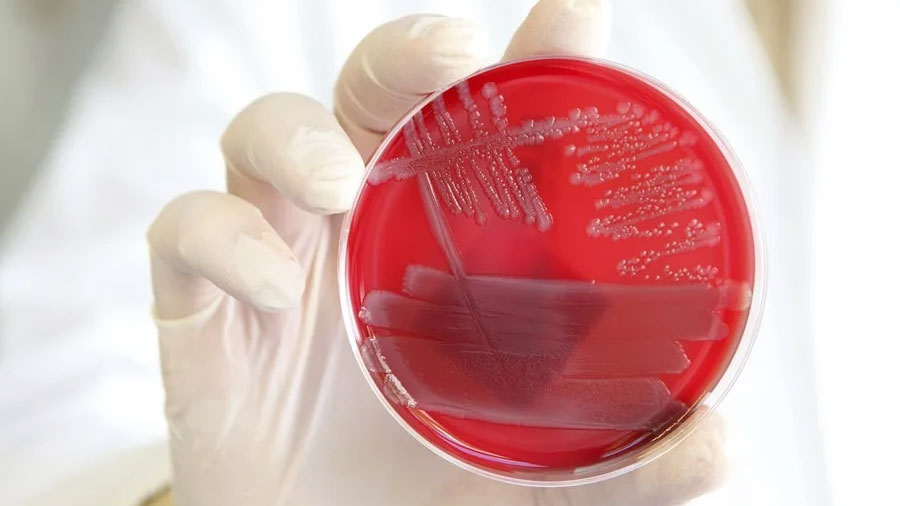

Pruebas adicionales revelaron que una epoxioxilipina (la 12,13-EpOME) actúa desactivando una señal proteica llamada p38 MAPK, que impulsa la transformación de los monocitos intermedios
Un equipo de investigadores del University College London ha descubierto un mecanismo clave que ayuda al cuerpo a desactivar la inflamación, un avance que abre la puerta a nuevos tratamientos para las enfermedades autoinmunes que afectan a millones de personas. Sus conclusiones aparecen recogidas este viernes en Nature Communications.
La inflamación es la primera línea de defensa del cuerpo contra infecciones y lesiones, pero cuando no se desactiva correctamente, puede provocar afecciones graves como artritis, diabetes o tantas otras.
El mecanismo por el cual el cuerpo decide detener su respuesta inmunitaria, o hacerla menos desproporcionada, y comenzar la curación ha sido una incógnita para la ciencia.
Moléculas de la grasa corporal
Ahora, este estudio revela que unas diminutas moléculas derivadas de la grasa corporal llamadasepoxioxilipinas actúan como frenos naturales del sistema inmunitario, evitando el crecimiento excesivo de ciertas células inmunes, conocidas como monocitos intermedios, que pueden causar inflamación crónica.
Para comprobar su tesis, los investigadores administraron a voluntarios humanos sanos una pequeña inyección de la bacteria ‘Escherichia coli’ ya muerta en el antebrazo, lo que desencadenó una reacción inflamatoria de corta duración (dolor, enrojecimiento, calor e hinchazón) similar a la que se produce después de una infección o lesión.
Los voluntarios se dividieron en dos grupos: el grupo profiláctico y el grupo terapéutico. A ambos grupos se les administró en varios momentos un fármaco llamado GSK2256294, que bloquea una enzima conocida como epoxida hidrolasa soluble (sEH), que descompone de forma natural las epoxioxilipinas.
Los 24 participantes del grupo profilactico (12 fueron tratados y 12 placebo) recibieron el fármaco dos horas antes de que comenzara la inflamación, para ver si el aumento temprano de las epoxioxilipinas podía prevenir cambios inmunitarios perjudiciales.
Los 24 participantes del grupo terapeútico (mitad tratados mitad placebo) recibieron el fármaco cuatro horas después del inicio de la inflamación, imitando el tratamiento real una vez que aparecen los síntomas.
En ambos grupos se vio que el bloqueo de la (sEH) aumentaba los niveles de epoxioxilipinas, aceleraba la resolución del dolor y reducía drásticamente los niveles de monocitos intermedios en sangre y tejidos, es decir de las células inmunitarias relacionadas con la inflamación crónica y la enfermedad.
Curiosamente, el fármaco no alteró significativamente los síntomas externos, como enrojecimiento y/o hinchazón.
Calmar al sistema inmune
Pruebas adicionales revelaron que una epoxioxilipina (la 12,13-EpOME) actúa desactivando una señal proteica llamada p38 MAPK, que impulsa la transformación de los monocitos intermedios. Esto se confirmó en experimentos de laboratorio y en voluntarios a los que se les administró un fármaco bloqueador de la p38.
“Nuestros hallazgos revelan una vía natural que limita la expansión dañina de las células inmunitarias y ayuda a calmar la inflamación más rápidamente” señala una de las autoras, la investigadora Olivia Bracken, del University College de Londres, en un comunicado del centro.
“Centrarse en este mecanismo podría conducir a tratamientos más seguros que restablezcan el equilibrio inmunitario sin suprimir la inmunidad general como ocurre con los tratamientos que hay ahora. Este descubrimiento abre una vía prometedora para nuevas terapias”, añade.
Fuente: eldia.com